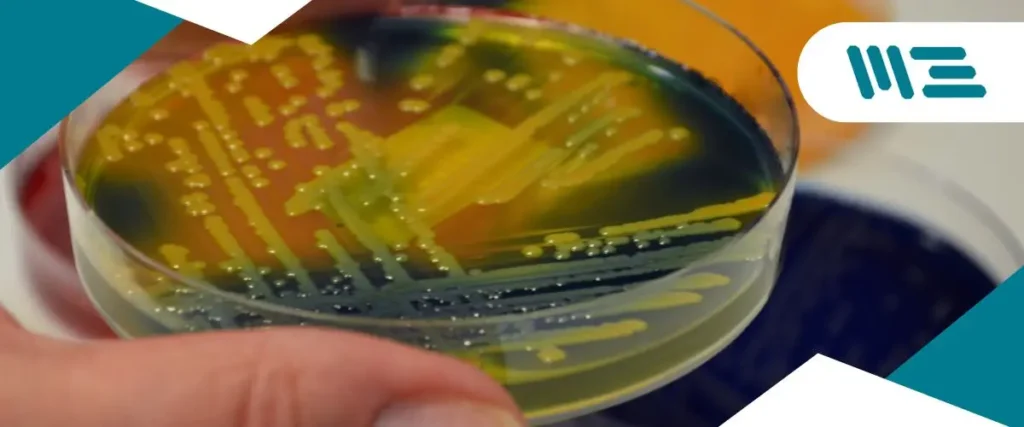
Eliminación y control de biofilms: claves para la seguridad alimentaria Implementa métodos efectivos para la eliminación de biofilms y asegura el cumplimiento de normativas alimentarias.

Los biofilms son un enemigo silencioso en la industria alimentaria. Invisibles a simple vista, estos microbios pueden desarrollarse en las superficies de tu planta, generando problemas que afectan la calidad de tus productos y ponen en riesgo la salud de tus consumidores. La gran pregunta que te debes estar haciendo es: ¿cómo controlarlos sin afectar la maquinaria ni los procesos productivos? Hoy te lo explicamos.
¿Qué son los biofilms y por qué son tan peligrosos?
Los biofilms son comunidades de microorganismos que se adhieren a las superficies formando una capa resistente y difícil de eliminar. Este proceso ocurre especialmente en áreas difíciles de limpiar, como conductos, tuberías y superficies en contacto con alimentos. Lo preocupante es que los biofilms protegen a las bacterias de los agentes químicos y los procedimientos de limpieza convencionales, lo que dificulta su eliminación.
Impacto de los biofilms en la seguridad alimentaria
El principal riesgo de los biofilms es la contaminación alimentaria. Patógenos como la Listeria monocytogenes y Salmonella encuentran en estas biopelículas el ambiente perfecto para sobrevivir y multiplicarse. La presencia de biofilms en una planta puede provocar fallas en auditorías de calidad, retiro de productos del mercado y, lo más grave, enfermedades en los consumidores.

Métodos efectivos para eliminar biofilms sin dañar la maquinaria
La clave para el control de los biofilms está en combinar productos químicos efectivos y técnicas avanzadas de limpieza. Algunos métodos incluyen:
- Limpieza en espuma: La espuma se adhiere a las superficies, actuando sobre las capas de biofilms y permitiendo que los químicos penetren y eliminen las bacterias. Es ideal para áreas grandes como mesas de producción y transportadores.
- CIP (Clean-In-Place): Esta técnica permite limpiar equipos sin necesidad de desmontarlos, aplicando químicos de forma automática a través de tuberías y sistemas cerrados.
- Desinfectantes oxidantes: Productos como el ácido peracético y el cloro activo son efectivos para romper las paredes celulares de los microorganismos, eliminando los biofilms en su totalidad.
Pero el éxito no solo depende del método utilizado, sino también de la frecuencia y los procedimientos específicos de cada planta.
Cumplimiento de normativas internacionales y elección de productos químicos
El uso de productos químicos no es suficiente. También debes asegurarte de cumplir con las normativas internacionales de inocuidad alimentaria como las establecidas por la FDA, la ISO 22000 o los estándares GFSI.
¿Qué productos químicos son los más recomendados?
- Alcalinos fuertes como el hidróxido de sodio (sosa cáustica) son ideales para eliminar grasa y proteínas.
- Ácidos como el nítrico son eficaces para remover depósitos minerales.
- Desinfectantes clorados son especialmente útiles para reducir cargas microbianas.
El secreto es elegir productos químicos especializados que aseguren la eliminación de biofilms sin afectar los equipos o la seguridad de los trabajadores.
Monitoreo y validación del programa de limpieza y desinfección
Implementar un programa integral de limpieza no es suficiente. Debes contar con un sistema de monitoreo y validación que garantice la eliminación continua de biofilms. Para esto, te recomendamos:
- Pruebas microbiológicas: Realizar hisopados de superficies críticas y analizar los resultados en laboratorios especializados.
- Bioluminiscencia: Una técnica que mide la presencia de ATP, un indicador de contaminación biológica, para evaluar la efectividad de la limpieza en tiempo real.
- Vigilancia continua: El monitoreo regular mediante registros de limpieza y protocolos validados es esencial para cumplir con los estándares internacionales.
Costos y recursos necesarios para implementar un programa de control de biofilms
Uno de los mayores desafíos al implementar un programa de control de biofilms es calcular los costos. Estos pueden variar dependiendo del tamaño de tu planta, el nivel de automatización y los productos químicos necesarios.
- Mano de obra: La capacitación del personal es crucial para asegurar que se apliquen los procedimientos de manera correcta.
- Productos químicos: Los costos pueden variar según el tipo y cantidad de desinfectante necesario para mantener la planta libre de biofilms.
- Tiempo de inactividad: La limpieza de equipos y superficies puede requerir tiempo, lo que implica detener la producción temporalmente.
A largo plazo, una correcta implementación reduce los costos operativos y minimiza las interrupciones derivadas de problemas de calidad o contaminación.
Certificaciones y herramientas para garantizar el control de biofilms
Obtener certificaciones como la ISO 22000 o la FSSC 22000 no solo asegura la calidad de tus productos, sino que también te permite abrirte a mercados internacionales. Estas certificaciones requieren demostrar que cuentas con protocolos de control de biofilms efectivos.
Además, necesitarás utilizar herramientas de monitoreo avanzado y realizar auditorías regulares para mantenerte en cumplimiento con las normativas vigentes.
El control de biofilms es crucial para la seguridad y el éxito de tu planta
Prevenir y eliminar los biofilms en tu planta es una prioridad para mantener la seguridad alimentaria y cumplir con las normativas. Los métodos y productos que utilices deben adaptarse a las necesidades específicas de tus instalaciones, siempre asegurando que no afecten la maquinaria ni los equipos. Un enfoque integral que incluya monitoreo, capacitación y validación garantizará que tu planta esté preparada para cualquier auditoría o inspección.
Contáctanos hoy para descubrir cómo podemos ayudarte a llevar tu empresa al siguiente nivel. Nuestro equipo de expertos está listo para guiarte en el proceso de certificación y ayudarte a mejorar tu competitividad en el mercado global.
¡No dudes en contactarnos para obtener más información sobre cómo podemos ayudarte!
En M3 Consulting somos líderes en el sector alimentario con una larga trayectoria respaldada por años de experiencia y por los testimonios de nuestros clientes.